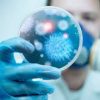

شدد طبيب الأطفال الألماني هانز يورغين نينتفيش على ضرورة ألا يدخن الآباء في البيئة المحيطة بالطفل الرضيع؛ لأن دخان السجائر يعرض الرضيع لخطر الموت المفاجئ أثناء النوم. وأضاف نينتفيش، عضو الرابطة الألمانية لأطباء الأطفال والمراهقين، أن خطر الموت المفاجئ يُحدق بالرضيع أيضاً، في حال نومه مع الوالدين في سرير واحد أو على أريكة واحدة.
ولتجنب هذا الخطر، أوصى طبيب الأطفال الألماني بأن ينام الطفل في سرير خاص به في غرفة نوم الوالدين، كي يتمكنوا من ملاحظة أية تغيرات صحية طارئة عليه، مع مراعاة أن ينام الرضيع على ظهره داخل كيس نوم مخصص للرضع، وأن تتراوح درجة حرارة الغرفة بين 18 و20 درجة مئوية.
ومن المهم أيضاً أن يخلو السرير من الأغطية أو الدمى؛ لأنها ربما تنزلق وتغطي وجه الرضيع، ومن ثم تعرضه لخطر الاختناق. وبالإضافة إلى ذلك، ينبغي الالتزام بالتطعيمات المقررة للطفل، وإرضاعه طبيعياً لأطول فترة ممكنة من أجل تقليل خطر تعرضه للموت المفاجئ.